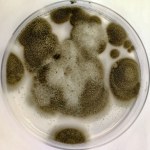
grzyb Grzyb z Czarnobyla zaskoczył naukowców. Budzi zainteresowanie agencji kosmicznych

grzyb
- Wszystkie (18)
- Artykuły (18)
Artykuły (18)
-
Grzyb z Czarnobyla zaskoczył naukowców. Budzi zainteresowanie agencji kosmicznych
- Środa, 3 grudnia 2025 (13:29)
-
Muchomor na talerzu? Śmiertelnie groźny trend w sieci
- Niedziela, 19 października 2025 (13:24)
-
Palce diabła znowu wyrosły na Podhalu. Czy wiedzieliście o istnieniu takiego grzyba?
- Piątek, 23 września 2022 (14:42)
Można go spotkać od lipca do października w młodych lasach liściastych i mieszanych, najczęściej w sąsiedztwie brzozy brodawkowatej, sosny oraz topoli, osiki, w zaroślach, na obrzeżach...Podhale, grzyb